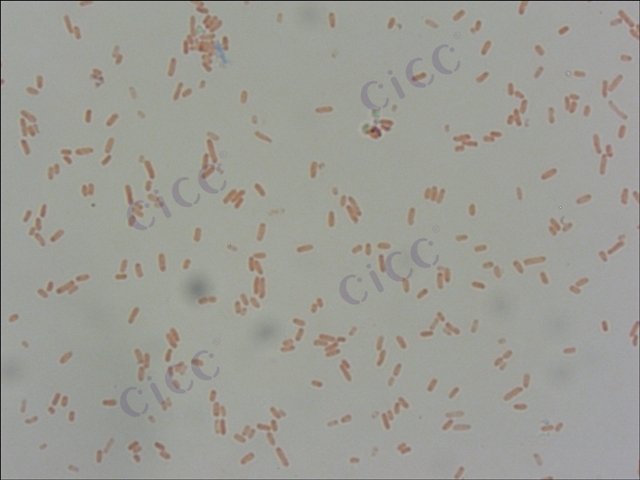
小肠结肠炎耶尔森氏菌 Yersinia enterocolitica CICC 10869 Yersinia enterocolitica

小肠结肠炎耶尔森氏菌 Yersinia enterocolitica CICC 10869 Yersinia enterocolitica
-
小肠结肠炎耶尔森氏菌 Yersinia enterocolitica CICC 21669 Yersinia enterocolitica
CICC 21669 | 见证书
-
小肠结肠炎耶尔森氏菌 Yersinia enterocolitica CICC 25338 Yersinia enterocolitica
CICC 25338 | 见证书
-
小肠结肠炎耶尔森氏菌 Yersinia enterocolitica
BNCC369834 | 冻干粉;斜面;菌液;平板
-
小肠结肠炎耶尔森氏菌 Yersinia enterocolitica
BNCC336699 | 冻干粉;斜面;菌液;平板
-
小肠结肠炎耶尔森氏菌 Yersinia enterocolitica
BNCC186042 | 冻干粉;斜面;菌液;平板
-
小肠结肠炎耶尔森氏菌小肠结肠炎亚种 Yersinia enterocolitica subsp. enterocolitica
BNCC361779 | 冻干粉;斜面;菌液;平板
-
小肠结肠炎耶尔森菌 Yersinia enterocolitica subsp. enterocolitica ATCC 9610 Culti-Loop Yersinia enterocolitica subsp. enterocolitica ATCC® 9610™
R4609018 | 5支/包

说明书下载: 菌种说明书 打管说明书
您正在浏览的产品:小肠结肠炎耶尔森氏菌 Yersinia enterocolitica CICC 10869
手机版:小肠结肠炎耶尔森氏菌 Yersinia enterocolitica CICC 10869
本公司销售的所有产品仅供实验科研使用,不用于人体及临床诊断。
2. 选择性分离:CIN-1琼脂平板与改良Y培养基双重筛选,26℃±1℃培养48h
3. 生化鉴定:改良克氏双糖铁琼脂、尿素酶试验、糖发酵试验等[1][5][7]
2. 动力试验:半固体琼脂26℃培养观察动力特征
3. 血清学验证:使用多价O因子血清进行凝集试验[1][5]
2. 双重PCR检测:靶向ail和virF毒力基因
3. 脉冲场凝胶电泳分型[1]
2. 毒力基因检测:需同时扩增16S rRNA作为内参
3. 生物分型:通过木糖、蔗糖发酵试验划分生物型[1]
以上信息仅供参考,请以相应标准的原文为准!